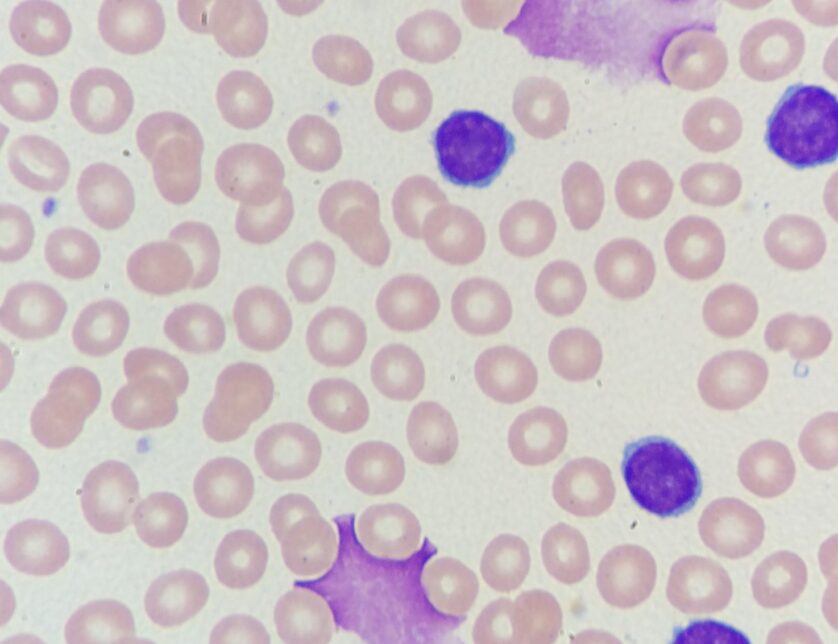

We’re opening applications for 30 dedicated professionals to take part in our upcoming Advancing CLL course. This is your chance to deepen your understanding and grow your impact.

We’re opening applications for 30 dedicated professionals to take part in our upcoming Advancing CLL course. This is your chance to deepen your understanding and grow your impact.